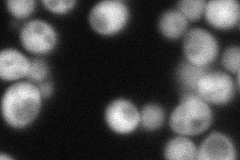
YDR009W

View description
Transcriptional regulator involved in activation of the GAL genes in response to galactose; forms a complex with Gal80p to relieve Gal80p inhibition of Gal4p; binds galactose and ATP but does not have galactokinase activity
Localization:
Intensity:
Fold change:
Significance:
-
C’ GFP library in SD

below threshold18.05 -
N' NOP1pr-GFP in SD

cytosol79.4199 -
N' TEF2pr-mCherry in SD
cytosol71.595 -
N' NATIVEpr-GFP in SD

below threshold24.6277 -
N' TEF2pr-VC and Cyto-VN in SD

cytosol45.4023 -
C’ GFP library in SD+DTT

cytosol21.651.19No -
C’ GFP library in SD+H2O2

cytosol16.940.93No -
C’ GFP library in Starvation Media

cytosol18.040.99No -
C’ GFP library on the background of Pup2-DaMP

below threshold -
C’ GFP library on the background of CCT mutant

below threshold19.31361.06953No
